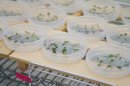

植物が備える力に着目し、植物ホルモンの働きと再生の原理から生命の可能性を拓く<東洋大学SDGs NewsLetter Vol.39>
配信日時: 2025-09-26 12:00:00

気候変動や人間活動によって、希少植物の絶滅など、生物多様性の損失が深刻化しています。危機的状況の中で重要視されているのが、化学肥料に頼るのではなく、植物本来の生命力や環境適応力を引き出すアプローチです。植物ホルモンの働きにまつわる植物の再生能力や生存戦略について、東洋大学生命科学部生物資源学科の梅原教授がお話します。
[画像1]https://digitalpr.jp/table_img/2714/118734/118734_web_1.png
植物本来の生命力が未来の農業の鍵となる
──植物ホルモン「ストリゴラクトン」について、具体的に教えてください。
私が2008年に発見したストリゴラクトンは、植物が過酷な環境を生き延びる上で、重要な役割を果たす植物ホルモンです。植物の栄養状態が悪化すると分泌され、限られた栄養を最大限に活かすために複合的な働きをします。ストリゴラクトンの主な作用は、栄養を温存する働きと、より多くの栄養を取り込む働きの二つ。温存する面においては、古い葉の老化を促進して古い葉から新しい若い葉へ効率的に栄養を回し、同時に枝分かれを抑制して無駄な成長を抑えます。一方、栄養吸収の効率化の面では、根に共生する菌(アーバスキュラー菌根菌)を活性化させて土壌からより多くの栄養を吸収するほか、葉の角度を調整して光合成効率を向上させます。
ストリゴラクトンは基本的にどの植物にも存在するホルモンですが、具体的な作用メカニズムについてはまだ解明の途上にあります。
[画像2]https://digitalpr.jp/simg/2714/118734/600_399_2025092515032368d4db2b05927.jpg
──農業分野や園芸分野にはどのような影響が期待できるのでしょうか。
もともと植物ホルモンは収量と密接に関わっており、ストリゴラクトンを効果的に応用すれば、作物の栄養吸収効率や食栄養に対する耐環境性が向上し、収量を増加させることができると考えています。加えて、ストリゴラクトンはイネの胚乳の大きさを適切にコントロールする役割も担っています。
また、根寄生植物対策としても活用が可能です。例えば、アメリカやチリ、トルコなどの広大な農場では、根寄生植物によるトマトへの深刻な農業被害が知られています。除草剤ではトマト本体にも悪影響があるため、これまで有効な対抗手段がありませんでしたが、根から分泌されるストリゴラクトンがトマトに寄生する植物の発芽率に影響することがわかっています。そのため、根からストリゴラクトンを分泌しないトマトを育種することで、根寄生植物の寄生を抑制して、トマトの収量増が期待できます。
異常気象の影響で、害虫や生育不良といった問題が生じている現代農業において、ストリゴラクトンは作物(農業)生産の安定化にとどまらず、労働負担の軽減にも寄与できる可能性があります。気候変動をはじめとした地球規模の課題に対し、植物ホルモンがどこまで有効な解決策となるかは今後の研究成果次第ですが、将来きっと重要な役割を果たしてくれるでしょう。
驚異的な再生機能で、自ら芽吹く薬用植物「トコン」
──ストリゴラクトンと並んで注目されている薬用植物「トコン」について教えてください
私の研究対象の一つであるトコンは、南米原産の薬用植物です。古来から催吐剤や去痰剤等に効果のある医薬品原料として利用されてきましたが、乱獲により個体数が激減。そのため、原産国のブラジルでは絶滅が心配されている植物です。
特に注目しているのは、トコンが持つ驚異的な再生機能です。多くの植物は、培養する際に培地に植物ホルモンを添加する必要がありますが、トコンは植物ホルモンの添加を必要とせず、茎を切り出すだけで新しい芽を形成できます。これは、自ら植物ホルモンの産生を活性化させて成長できるという珍しい特性で、植物の再生生物学のモデルとしても高い関心を集めています。
私たちの研究の結果、トコンの再生機能には、茎内部のホルモン濃度バランスの調整が関係していることがわかりました。通常、植物ホルモンの一種であるオーキシンは茎の先端(茎頂)で分泌され、根元に向かって流れます。しかし、茎頂を除去した場合、茎断片の茎頂側ではオーキシン濃度が低下し、別の植物ホルモンであるサイトカイニンの合成が進みます。このサイトカイニンの合成が茎の表皮で活性化することで、新しい芽が形成されると考えられています。
[画像3]https://digitalpr.jp/simg/2714/118734/600_399_2025092515034168d4db3ded920.jpg
──研究の社会的意義についてはどのようにお考えでしょうか。
トコンの持つ機能を解明し、再生が難しい植物へ応用することで、希少植物や絶滅危惧種の保全等に役立てられる可能性があります。
また、商品価値の高い植物のクローン増殖も容易になるでしょう。ブラジルのような熱帯に生息する植物は再生機能が高い傾向にあり、これは温度や天候の大きな変化に耐え抜くための生存戦略だと考えられます。トコンの再生システムを解明できれば、近年の激しい気象変動に適応できる新たな作物開発に応用できるかもしれません。近年、日本でも台風や猛暑といった異常気象が頻発しています。過酷な環境下でも安定した収量を確保できる作物の存在は、食料安全保障の観点からも非常に重要です。
「増」をキーワードに、諸分野の発展を目指して
──今後のビジョンについてお聞かせください。
私が掲げる次のキーワードは「増」です。一つは、植物ホルモンのストリゴラクトンを活用し、農作物や有用植物の生産量を増やして収量を向上させること。もう一つは、トコンの再生機構の解明を通して再生が難しい植物の増殖を可能にし、クローン植物の可能性を広げることです。
私一人の取り組みには限りがあるため、今後はさらに多くの分野の研究者や企業と連携を深めたいと考えています。お互いの知見を活かして課題解決に取り組み、持続可能性を意識しながら共同研究の輪を広げていく。そのプロセスが農業や園芸をはじめとする諸分野のさらなる発展につながるはずです。そして、将来的には植物の成長をコントロールする新たな植物ホルモンの発見にも挑戦したいと考えています。
[画像4]https://digitalpr.jp/simg/2714/118734/400_266_2025092515014868d4dacc971e2.jpg
梅原 三貴久(うめはら みきひさ)
生命科学部生物資源学科教授/博士(理学)
専門分野: 基礎生物学/植物分子・生理科学/農芸化学/植物栄養学・土壌学 研究キーワード:植物生理学/植物バイオテクノロジー/植物ホルモン 著書・論文等:Ectopic expression of LONELY GUY7 in epidermis of internodal segments for de novo shoot regeneration without phytohormone treatment in ipecac 等
本件に関するお問合わせ先
東洋大学総務部広報課
mlkoho@toyo.jp
取材お申し込みフォーム
https://www.toyo.ac.jp/press/
関連リンク
東洋大学SDGs NewsLetter一覧
https://www.toyo.ac.jp/sdgs/newsletter/
東洋大学SDGs特設サイト
https://www.toyo.ac.jp/sdgs/
プレスリリース情報提供元:Digital PR Platform
スポンサードリンク
「国・自治体・公共機関」のプレスリリース
スポンサードリンク
最新のプレスリリース
- 極限の速度と音圧で魂を解き放て! 『MEGATON KICK ‘26』 唯一無二の音ゲー系イベント 2月8日(日)開催!11/22 20:00
- 千葉県館山市在住の難病患者チエさんを支援するクラウドファンディングがスタート〜「誰かを応援したい」という想いを循環させる挑戦〜11/22 19:10
- 2026年2月14日頃発売予定大人気中華BL小説「死亡万華鏡」第1巻表紙を初公開!11/22 18:00
- 大人気中国BLファンタジー小説『二哈和他的白猫師尊』本編完結編7・8巻が本日発売に!11/22 18:00
- 中国ドラマ『九重紫』DVD-SET発売決定!本日より予約受付開始!発売日と同日にレンタルもスタート!11/22 18:00
- 最新のプレスリリースをもっと見る
